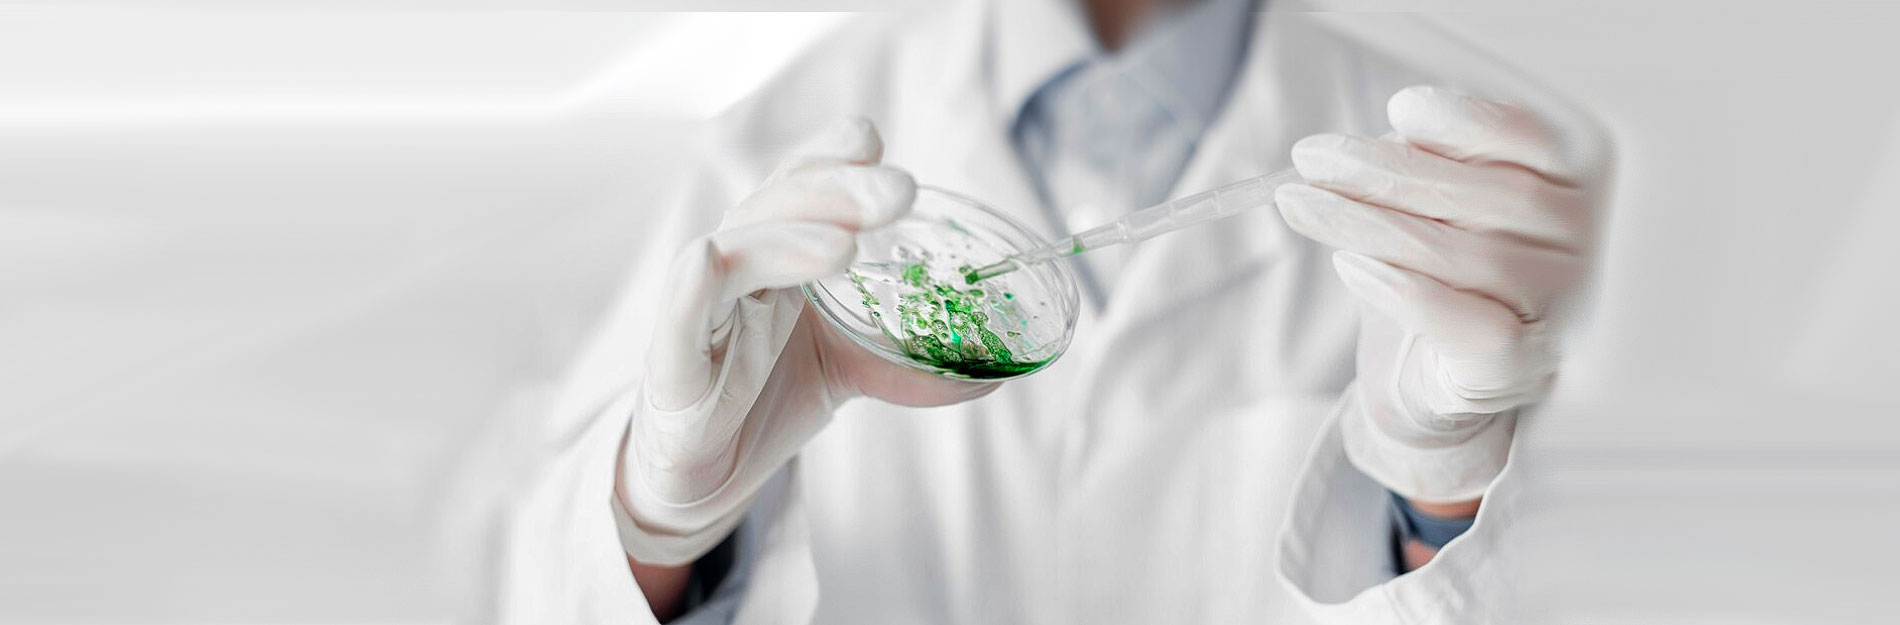

Biocatálisis enfocada en la sostenibilidad
María Guadalupe Sánchez-Otero
Ver en el PDF
En todos los organismos vivos, desde los unicelulares hasta los más complejos como los mamíferos superiores, la supervivencia depende de reacciones químicas necesarias para construir biomoléculas o para obtener energía de ellas; este proceso se conoce como metabolismo y no podría ocurrir sin la ayuda de moléculas llamadas enzimas. Las enzimas, al reducir la energía de activación, aceleran las reacciones químicas esenciales para la vida, y debido a que son las responsables de la catálisis de reacciones químico-biológicas, se les denomina “biocatalizadores” (Nelson et al., 2018).
Las enzimas son moléculas de origen proteico conformadas por un determinado número de aminoácidos con una cierta secuencia, unidos entre sí y que se pliegan en una forma tridimensional específica; esta forma o plegamiento define la reacción específica que catalizará cada una de ellas.
La catálisis se lleva a cabo una vez que las enzimas reconocen sustratos específicos en un lugar llamado sitio activo, que es el espacio en su estructura que puede llevar a cabo reacciones químicas. Las enzimas pueden ser sujetas a regulación e inhibición; algunas enzimas necesitan un constituyente adicional denominado cofactor, tal como algunos iones inorgánicos o alguna molécula orgánica o metalo-orgánica compleja llamada coenzima. La actividad enzimática se ve influenciada por cambios en el pH, la temperatura y las condiciones del medio. Las enzimas se nombran comúnmente según la reacción en la que participan con la terminación “asa”, por ejemplo, una ligasa es aquella que crea un enlace o “liga” para unir dos moléculas. También hay un sistema de nomenclatura que usa el nombre del sustrato y el tipo de reacción, por ejemplo, la glucosa oxidasa. Cuando existe un conjunto de enzimas para un proceso se le llama “sistema”, como el sistema de succinato oxidasa, formado por al menos dos enzimas (Nelson et al., 2018).
BIOCATÁLISIS: INICIO Y ESTADO ACTUAL
La acción catalítica de las enzimas se conoce desde principios del siglo XIX; las primeras conocidas fueron enzimas hidrolíticas tales como la pepsina. El concepto de catalizadores también surge en esa época, junto con el conocimiento de que las enzimas se comportaban como catalizadores. A inicio del siglo XX se llevó a cabo la primera síntesis enantioespecífica, es decir, con un reconocimiento altamente específico de la conexión, posición y orientación de los enlaces químicos que utilizaba enzimas, y se realizó para producir un compuesto denominado (R)-mandelonitrilo, con el uso de un extracto vegetal que contenía una enzima llamada hidroxi-nitrilo liasa; se considera que con este descubrimiento inicia el campo de la biocatálisis, concepto que se puede definir como el uso de moléculas biológicamente activas para catalizar transformaciones químicas. A partir de ese momento, el avance en la biocatálisis y sus aplicaciones ha sido constante, y en las últimas décadas se ha desarrollado rápidamente. En un principio, se usaron enzimas crudas, es decir, como se obtienen directamente de los organismos, ya sea extrayéndolas o produciéndolas en cultivos. Posteriormente, se pudo hacer uso de enzimas purificadas, y al llegar las técnicas de biología molecular para producir enzimas recombinantes (se producen usando los genes de una especie expresados en bacterias, hongos, células cultivables de plantas y animales, que no sintetizan estas proteínas de manera natural). Con todo lo anterior, de acuerdo con Heckmann y Paradisi (2020), la biocatálisis se ha revolucionado y ha avanzado con la ingeniería de enzimas, permitiendo la creación de biocatalizadores altamente específicos y eficientes. Actualmente se hacen mejoras en la estructura de las enzimas con herramientas de bioinformática; así, se pueden modificar las condiciones de reacción, la forma de la enzima (soluble o inmovilizada), o realizar evolución dirigida para obtener enzimas cada vez más eficientes y resistentes.
En particular, el uso de enzimas inmovilizadas (aquellas que están confinadas o unidas a un material sólido que funciona como soporte) permitió un gran avance, ya que estas biomoléculas, al ser proteínas, están sujetas a desnaturalización por la temperatura y otros factores, y al ser solubles, son difíciles de recuperar del medio e imposibles de ser reusadas. Con la inmovilización, se obtienen derivados estables, fácilmente recuperables del medio de reacción y con capacidad de reutilización (Maghraby et al., 2023).
ENZIMAS APLICADAS A BIOCATÁLISIS INDUSTRIAL
La fuente más común para obtener enzimas para aplicaciones industriales son los microorganismos (bacterias, hongos y levaduras), ya que proporcionan ventajas sobre las enzimas de origen animal o vegetal: tienen una alta velocidad de replicación, una disponibilidad constante, alta producción y la posibilidad de aplicar métodos de cultivo para cada tipo de microorganismo. En esos cultivos, los microorganismos pueden producir enzimas y liberarlas hacia el medio. Para algunas aplicaciones, las enzimas pueden usarse directamente de estos medios o con unos pocos pasos de purificación; sin embargo, las enzimas usadas para fines terapéuticos o para pruebas diagnósticas requieren un grado de pureza del 100 %. Actualmente, las enzimas recombinantes se pueden obtener en grandes cantidades y de forma relativamente sencilla, y tienen características similares o mejores que las de la enzima nativa (Arroyo, 2014).
Entre las enzimas más populares para aplicaciones industriales se encuentran las oxidorreductasas y las hidrolasas; las primeras se encargan de catalizar reacciones de transferencia de electrones (reacciones redox), y las segundas catalizan la descomposición de moléculas grandes en unidades más pequeñas en presencia de agua (Fasim et al., 2021).
Las principales aplicaciones de las enzimas están en la industria alimentaria en procesos tales como la clarificación de jugos, la modificación de grasas lácteas, la hidrólisis de proteínas y la producción de sabores; en la industria farmacéutica se usan para la síntesis de fármacos e intermediarios específicos; en el área de la salud, para la producción de biosensores y kits de análisis clínicos; en la industria de los detergentes, como aditivos para formulaciones industriales y de uso casero; además, se emplean en las industrias peletera, papelera y textil. Un campo importante es el que tiene que ver con procesos aplicados para la sostenibilidad (Arroyo, 2014; Fasim et al., 2021).
BIOCATÁLISIS Y SOSTENIBILIDAD
La sostenibilidad se refiere a que las actividades humanas estén en equilibrio entre el desarrollo económico, social y ambiental para satisfacer las necesidades de la población actual sin comprometer las necesidades de las futuras generaciones; para ello es necesario utilizar los recursos naturales de manera responsable y adaptar los quehaceres humanos a los 17 objetivos del desarrollo sostenible (ODS), entre los que se encuentran la garantía de una educación de calidad, la promoción de la igualdad de género, la acción contra el cambio climático, la garantía de energía asequible y no contaminante y la de agua limpia y saneamiento para todos (Organización de las Naciones Unidas [OMS], 2023).
Existen áreas en las cuales la biocatálisis puede ser utilizada para apoyar al cumplimiento de estos ODS mediante el aprovechamiento de residuos para producir derivados con uso posterior (biorrefinería), la producción de combustibles (biocombustibles), la degradación de contaminantes y la recuperación de suelos y cuerpos de agua (biorremediación), tal como se muestra en la Figura 1.
BIORREFINACIÓN Y BIOCOMBUSTIBLES
La biorrefinación es el conjunto de procesos sostenibles encaminados a la obtención de productos de valor agregado necesarios para el quehacer humano a partir de materias primas que fundamentalmente son residuos agroalimentarios, de una manera semejante como hacen las refinerías tradicionales en las que, a partir de petróleo crudo, se generan productos como gasolina, polímeros y otros productos químicos. La biocatálisis es y será esencial para establecer una economía circular, es decir, aquella que optimiza los procesos, minimiza la generación de residuos al medioambiente y fomenta la reutilización y el reciclaje (Ezeorba et al., 2024).
El tipo de residuo es el que marca la pauta para el proceso enzimático requerido, ya que su composición varía en dependencia de la industria que generó los desechos. En el futuro, la generación de residuos ricos en biomasa, asociada a la agricultura, estará enfocada en la producción de biocombustibles, edulcorantes, bioplásticos y prebióticos mediante el uso de hidrolasas tales como las xilanasas, celulasas, amilasas e isomerasas. La industria pesquera genera toneladas de residuos ricos en quitina, el biopolímero de los caparazones de los crustáceos que puede ser procesado con quitinasas para producir bioplásticos y otros derivados. La industria de producción de lácteos genera cantidades importantes de residuos altos en proteínas y lactosa como lo son los sueros derivados de la producción de caseínas y quesos, por lo que pueden usarse diversas proteasas, isomerasas y epimerasas para su aprovechamiento (Ottone et al., 2021).
Adicionalmente, en los residuos de origen vegetal existen compuestos que son parte del metabolismo secundario de las plantas y que les son útiles como defensa o factores de crecimiento, y muchos de ellos tienen propiedades biológicas importantes y pueden ser usados como nutraceúticos o como ingredientes en cosméticos y fármacos, como agentes bactericidas, antiparasitarios, antifúngicos y antivirales. Estos compuestos se desaprovechan si los residuos vegetales no son biotransformados para su recuperación. Compuestos valiosos como polifenoles, carotenoides, terpenos, entre otros, pueden ser extraídos por procesos de biorrefinería con enzimas hidrolíticas como celulasa, amilasa y glucosidasas (Ezeorba et al., 2024).
La obtención de biocombustibles a partir de residuos agroalimentarios es ya posible con el uso de enzimas; el biogás, el bioetanol y el biodiesel ya se obtienen a partir de desechos procesados con enzimas, y cada vez más y más sectores se suman a investigar nuevas fuentes de biocatalizadores y nuevos procesos y tecnologías para mejorar los rendimientos. De maneral ideal, en el futuro, las biorrefinerías serán espacios donde carbohidratos y grasas serán la base de la producción de combustibles y de la generación de energía, y no los hidrocarburos; estas biorrefinerías serán fundamentales en la sostenibilidad y la economía circular (Haque et al., 2022)
El biodiesel, combustible producido a partir de residuos con altas concentraciones de grasas o aceites vegetales, se produce de manera sostenible con un grupo de enzimas muy versátiles llamadas lipasas que, de manera natural, hidrolizan las grasas; además, en presencia de solventes orgánicos pueden llevarse a cabo reacciones como la transesterificación, en la que los triacilglicéridos se transforman en los ésteres metílicos que constituyen el biodiesel. El bioetanol, por su parte, se produce a partir de la fermentación de residuos altos en carbohidratos, como la celulosa, la xilosa y la lignocelulosa, mediante mezclas de enzimas como celulasas y xilanasas para producir azúcares simples que después serán fermentados por levaduras o bacterias hasta producir etanol.
El biogás (mezcla de metano, hidrógeno y dióxido de carbono) generalmente se produce por reacciones de biodegradación de materia orgánica llevadas a cabo por microorganismos completos con sistemas de enzimas como hidrogenasas y nitrogenasas (Ezeorba et al., 2024; Haque et al., 2022).
BIORREMEDIACIÓN
La biorremediación es la restauración del equilibrio del medio ambiente mediante el uso de microorganismos o sus enzimas para degradar, eliminar, inactivar o transformar contaminantes de suelo, agua y aire que están presentes debido al daño provocado por la actividad industrial. La elección del método (mediante organismos vivos o solo enzimas) dependerá del grado de contaminación del ambiente y del tipo de contaminante. La biorremediación sustituye a los procesos que tradicionalmente se empleaban para revertir la contaminación de suelos, tales como la remoción y el confinamiento de estos, o la combustión y la exposición a radiación ultravioleta. Es necesario considerar que hay diversos factores que pueden determinar el éxito de la biorremediación, por ejemplo, la existencia de microorganismos naturales del lugar contaminado que pueden competir con las cepas agregadas (si se usan microorganismos); por otra parte, el contaminante debe ser accesible a ellos. Especial atención debe ponerse en los factores del entorno. En ese sentido, el uso de preparados enzimáticos tiene la ventaja de evitar preocupaciones sobre la supervivencia de los organismos biorremediadores ya que, a diferencia de los organismos vivos, las enzimas no requieren nutrientes, y el uso de enzimas inmovilizadas permite su reutilización (Haque et al., 2022; Ottone et al., 2021).
Las principales fuentes de contaminación de origen humano son las industrias metalúrgicas, las de producción de pesticidas, textiles y derivados químicos, el transporte, la industria petroquímica y la de producción de energía; todas ellas arrojan al medio ambiente compuestos orgánicos hidrocarburos y derivados, compuestos aromáticos halogenados, bifenilos policlorados, nitroaromáticos y metales pesados como mercurio, zinc, cromo, cadmio y plomo. Actualmente, se sabe que diversos compuestos producidos por el hombre son causa de riesgos metabólicos o endócrinos relacionados con obesidad y otros padecimientos. Uno de los obesógenos mejor caracterizados es el tributilestaño, que se utiliza ampliamente en la industria y en la agricultura y con el que el humano entra en contacto por medio del consumo alimentos, agua, microplásticos y superficies contaminadas (Ottone et al., 2021).
Las enzimas más utilizadas en los procesos de biorremediación son las oxidorreductasas, ya que tienen una alta capacidad de degradar contaminantes de origen orgánico tales como insecticidas, plaguicidas y diversos compuestos fenólicos e hidrocarburos; entre las más relevantes se encuentran las peroxidasas, que son oxidorreductasas que utilizan peróxido de hidrógeno para catalizar procesos oxidativos y son obtenidas de hongos y de vegetales como el rábano picante. Las lacasas son otro grupo de enzimas del grupo de las polifenoloxidasas capaces de oxidar compuestos carcinógenos tales como triclorofenoles, diversos pesticidas y tintes. Las azorreductasas pueden degradar a los colorantes azoicos hasta convertirlos en sus correspondientes colorantes menos dañinos. Existen también otras enzimas, tales como las monooxigenasas y las tirosinasas, que se pueden emplear como adyuvantes en la degradación de diversos contaminantes. (Haque et al, 2022; Ottone et al., 2021).
Para la inactivación o remoción de metales pesados en diversos ambientes, se ha explorado el uso de enzimas diversas, por ejemplo, cisteín-proteasas como la bromelaína (abundante en la piña) y la papaína (presente en el látex de papaya). Estos compuestos son eficientes en la remoción de plomo, níquel, mercurio y cobre. Las ureasas y lacasas de diferentes orígenes también han sido exitosamente utilizadas en la remoción de mercurio y cobre (Chatterjee et al., 2019).
CONCLUSIÓN
La capacidad catalítica de las enzimas las ha hecho insustituibles en áreas tales como las industrias alimentaria, peletera, papelera y farmacéutica, además de en la salud y el diagnóstico; indudablemente, contribuyen a que el quehacer humano sea más sostenible. En ese sentido, también pueden contribuir al establecimiento de un modelo de economía circular en todo el mundo y a revertir el impacto medioambiental que se genera por las actividades humanas. Por todo ello, es necesario continuar estudiando diversas fuentes de enzimas, así como las técnicas para su mejoramiento y aplicación.
REFERENCIAS
Arroyo M, Acebal C y Mata I (2014). Biocatálisis y biotecnología. Arbor 190(768):a156. https://doi.org/10.3989/arbor.2014.768n4010.
Chatterjee S, Pandit S and Fosso-Kankeu E (2019). Removal of Heavy Metal Pollutants from Wastewater Using Immobilized Enzyme Techniques: A Review. En E Fosso-Kankeu (Ed.), Nano and Bio-Based Technologies for Wastewater Treatment (pp. 459-479) John Wiley & Sons, Inc. https://doi.org/10.1002/9781119577119.ch13.
Ezeorba TPC, Okeke ES, Mayel MH, Nwuche CO and Ezike TC (2024). Recent advances in biotechnological valorization of agro-food wastes (AFW): Optimizing integrated approaches for sustainable biorefinery and circular bioeconomy. Bioresource Technology Reports 101823.
Fasim A, More VS and More SS (2021). Large-scale production of enzymes for biotechnology uses. Current Opinion in Biotechnology 69:68-76. https://doi.org/10.1016/j.copbio.2020.12.002.
Haque S, Singh R, Harakeh S et al. (2022). Enzyme-based biocatalysis for the treatment of organic pollutants and bioenergy production. Current Opinion in Green and Sustainable Chemistry 38:100709. https://doi.org/10.1016/j.cogsc.2022.100709.
Heckmann CM and Paradisi F (2020). Looking Back: A Short History of the Discovery of Enzymes and How They Became Powerful Chemical Tools. ChemCatChem 12(24):6082-6102. https://doi.org/10.1002/cctc.202001107.
Nelson DM y Cox M. Lehninger. Principios de Bioquímica. 7a Edición. España: Ed. Omega; 2018
Maghraby YR, El-Shabasy RM, Ibrahim AH and Azzazy HMES (2023). Enzyme immobilization technologies and industrial applications. ACS Omega 8(6):5184-5196. https://pubs.acs.org/doi/10.1021/acsomega.2c07560.
Organización de las Naciones Unidas [OMS]. (2023). Informe de los Objetivos de Desarrollo Sostenible 2023: Edición especial. Recuperado de: https://unstats.un.org/sdgs/report/2023/The-Sustainable-Development-Goals-Report-2023_Spanish.pdf.
Ottone C, Romero O, Urrutia P, Bernal C, Illanes A and Wilson L (2021a). Enzyme Biocatalysis and Sustainability. In: Piumetti, M., Bensaid, S. (eds) Nanostructured Catalysts for Environmental Applications. Springer, Cham. https://doi.org/10.1007/978-3-030-58934-9_14.